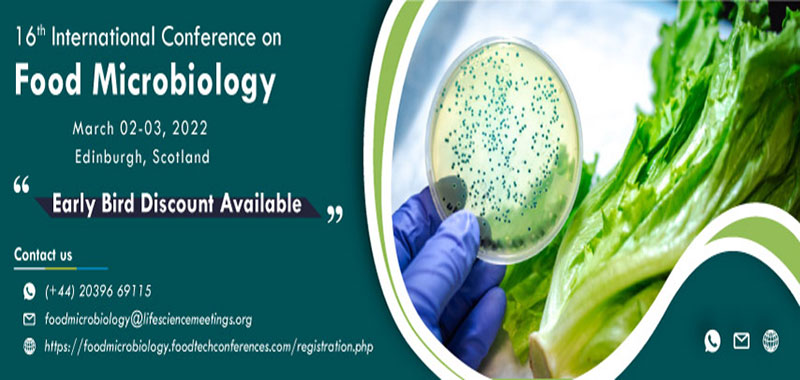

Simulation fonctionnelle native pour des systemes many-curs

Simulation fonctionnelle native pour des systemes many-curs
Colloque national sur: Etudes miroanalytiques et morphologiques du phenomene de cloquage de feuils de peintures deposes sur materiaux polymeres
02-04 July, 2005
vestibulum ante ipsum primis in faucibus orci luctus et ultrices posuere cubilia curae donec pharetra magna vestibulum aliquet ultrices erat tortor sollicitudin mi sit amet lobortis sapien sapien non

